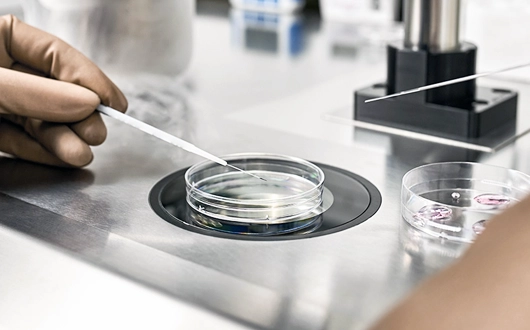

Taze embriyo transferi için, adetin 2. veya 3. günü yumurta büyütme işlemleri için hasta kliniğe davet edilir ve ultrason muayenesi yapılır.
Muayene neticesinde iğne tedavisi başlanır ve ortalama 10-12 gün içinde yumurta toplama işlemi gerçekleşir. Yumurta toplama işlemi sonrasında laboratuvar ortamında elde edilen 2, 3 veya 5. Gün embriyoları gelişim günlerine göre rahim içerisine ultrason eşliğinde ağrısız bir şekilde transfer edilir.
Tüp bebek tedavisinde embriyo dondurma, dünyada 30 yıldan fazladır kullanılmaktadır. Tüp bebek teknolojisinde gelişmeler neticesinde ilk embriyo transferi sonrasında çok sayıda embriyo geride kalmaktadır ve dondurulmaktadır. Bu sayede çiftler ilerleyen dönemlerde embriyo transferi ile çocuk sahibi veya kardeş sahibi olabilmektedirler.
Dondurulmuş embriyo transferi -196 derecede sıvı nitrojen tankları içerisinde dondurulmuş embriyoların günler, aylar veya yıllar sonra çözdürülüp embriyo transferi esasına dayanmaktadır.
Dünyada ilk tüp bebek Louise Brown 1978 yılında dünyaya gelmiştir. Dünyada ilk dondurulmuş embriyo transferi sonrasında doğan bebek Zoe Leyland 1984 yılında Avustralya da dünyaya gelmiştir.

1. Artmış yumurta sayısı: Tüp bebek tedavisi sürecine başlanılan hastaların yumurta toplama gününde 10 veya daha fazla yumurta toplanması halinde embriyoların dondurulması ve dondurulmuş embriyo transferi gerçekleştirilmesi taze embriyo transferine kıyasla daha yüksek gebelik oranına sahiptir. Bu nedenle yumurta toplama işlemi sonrasında yüksek sayıda yumurta toplanan hastalarda embriyo dondurmak ve transfer etmek daha uygundur.
2. Embriyo genetik test: Tüp bebek tedavisinde başarıyı artırmak için kullanılan yöntemlerden bir tanesi embriyo genetik test uygulamasıdır.
Tüp bebek tedavisine başlanılan çiftlerde embriyo oluşumu sağlandıktan sonra embriyolardan genetik testi için parça alınır ve genetik inceleme için teste gönderilir. Bu süreçte genetik test sonuçları çıkana kadar embriyolar dondurulabilir.
3.Tüp bebek başarısını olumsuz etkileyecek rahim hastalıkları: Tüp bebek tedavisine başlayan çiftlerin embriyo transferi gerçekleşmeden önce miyom, polip, rahim şekilsel bozuklukları gibi problemler nedeniyle kadının embriyo transfer öncesi operasyon geçirmesi gerekebilir. Bu durumda embriyolar öncelikle dondurulur ve gerekli işlemler tamamlandıktan sonra embriyo transfer süreci tamamlanır.
4. Tüp bebek tedavisi sırasında erken yumurta çatlaması veya progesteron hormon yükselmesi: Tüp bebek yumurta büyütme sırasında ilaçlar kullanılırken büyüyen yumurtalar erken çatlayabilir. İkinci olarak yumurta sayısı yüksek olan hastalarda yüksek dozda ilaç kullanılması aşırı hormon yanıtına neden olabilir. Her iki durumda progesteron hormonun yüksek çıkmasına neden olur. Bu durum rahim iç kılıfı ve embriyo ile arasında uyumsuzluk gelişmesine ve embriyo tutunma başarısı azalmasına neden olur. Bu iki durumda embriyo dondurulması ve sonrasında embriyo transfer başarısını artırmaktadır.
5. Ovaryen hiperstimulasyon Sendromu (yumurta aşırı uyarılmışlık sendromu) riski: Yumurta Aşırı Uyarılmış Sendromu (OHSS) özellikle polikistik over sendromlu hastalarda tüp bebek ilaçları kullanılırken hastada çok yüksek sayıda yumurta büyümesi veya çok sayıda yumurta gelişen hastalarda hCG isimli yumurta çatlatma iğnesi sonrasında yumurtaların aşırı büyümesi veya yumurta toplama işlemi sonrasında karında sıvı birikmesi ve buna bağlı problemleri ortaya çıkması durumudur. Bu durumun öngörüldüğü hastalarda yumurta çatlatma iğnesi değiştirilip (hCG yerine analog uygulaması) yumurta aşırı uyarılmışlık sendromu görülme sıklığı azaltılabilir. Fakat bu durumun ortaya çıkmasını azaltan çatlatma iğnesinin uygulanması halinde taze embriyo transfer uygulanması gebelik ihtimalini azaltmaktadır. Bu nedenle bu hastalarda dondurulmuş embriyo transferi uygulamak tüp bebek başarısını artırmaktadır.
6. Rahim iç kılıfı inceliği (ince endometriyum): Taze embriyo transferi planlanan hastaların yumurta çatlatma uygulanan gün rahim iç kılıfın kalınlığının 7 mm ve üzerinde olması önerilmektedir. Taze embriyo transferi planlanan ve bu rahim duvar kalınlığına ulaşmayan hastalarda embriyo dondurma işlem yapılıp embriyo transferi sonra planlanmalıdır.
Donmuş embriyo transferi adet gününden itibaren ortalama 15-20 gün içerisinde gerçekleştirilir. Bu süreçte özellikle rahim duvar hazırlık şekli zamanlama için belirleyici unsurdur.
Dondurulmuş embriyo transferi öncesinde uygulamalar ve günlük aktivite düzenlemeleri sonucu direk olarak olumlu olumsuz etkileyebilir.

Dondurulmuş embriyo transfer süreci birkaç aşamadan oluşmaktadır. Bunlar aşağıdaki şekilde özetlenebilir.
Planlanan embriyo transfer günü sabahında veya bir gün öncesinde uygun laboratuvar koşullarında embriyo çözülür ve canlılığı değerlendirilir.
Planlanan embriyo transfer gününde çözülmüş embriyolar sert veya yumuşak kateterler ile rahim içine transfer edilir. Transfer edilecek embriyo sayısı sağlık bakanlığının belirlediği doğrultuda tek veya çift olarak gerçekleştirilir.
Embriyo transferinden yaklaşık 10-14 gün sonra kanda gebelik testi yani beta- hCG hormonu seviyeleri ölçülür. Eğer test pozitif ise kullanılan ilaçlarlar ile ilgili tekrar program yapılır ve uygun zamana kadar bu ilaçlar devam edilir. Negatif test sonucu olması halinde kullanılan tıbbı tedavi ilaçlar kesilir.
Eğer dondurulmuş embriyo transferi sonrasında kalan embriyolar mevcutsa çiftin isteği doğrultusunda donmuş şekilde saklanabilir.
Amerikan yardımcı üreme teknolojileri derneği verilerine göre dondurulmuş embriyonun rahime tutunma şansı yaklaşık % 30-50 arasındadır. Fakat bu genel geçer bir veri olup çiftlerin yaşı, transfer edilen embriyo sayısı, transfer tekniği gibi parametrelerden etkilenmektedir.
Birkaç önemli faktör dondurulmuş embriyo tutunma şansını etkileyebilir:
Dondurulmuş embriyo transferinde tutunma embriyo transfer işleminden 6-10 gün içerisinde olur.
Dondurulmuş embriyo transferi sıklıkla progesteron hormunu kullanmaya başladıktan 5-7 gün sonra gerçekleşir.
Dondurulmuş embriyo transfer sonrasında embriyo 1-2 gün içerisinde rahim iç kılıfında en uygun yeri belirlemektedir. Sonrasında embriyo rahim iç kılıfı ile bilgi alışverişine başlar ve endometriyum denilen tabakanın içerisine gömülmeye başlar. Bu sıklıkla embriyo transferinden 3-4 gün sonra gerçekleşmeye başlar.
Bazı kadınlar embriyo tutunması sırasında lekelenme, kasık ağrısı, göğüste gerginlik ve hassasiyet, kasık ağrısı veya kramp şeklinde kasılmalar hissedebilir. Fakat bu semptomlar her kadında farklı derecelerde veya hiç hissedilmeyebilir.
Tüp bebek embriyo transferi sonrasında artan progesteron hormonunun etkisiyle kabızlık sorunu sıkça görülmektedir. Bu duruma engel olmak için yüksek lifli gıdaların tüketilmesi, bol sıvı tüketilmesi ilk planda önerilen beslenme yöntemleridir. Dirençli kabızlık durumunda embriyo transfer sonrasında hekiminizin önerisi doğrultusunda gayta yumuşatıcı ilaçlar kullanılabilir.
Tüp bebek embriyo transferi sonrası ilk 30 dakika yatak istirahati önerilir. Sonra hastalar günlük aktiviteye dönebilir. Embriyo transfer sonrasında günlerce sıkı yatak istirahati yapmak ile birkaç gün günlük aktiviteyi kısıtlamak gebelik sonuçları açısından aynıdır. Bu nedenle günlerce sıkı yatak istirahati veya hareketsiz kalmak gereksizdir.
Tüp bebek tedavisi embriyo transferi sırasında ve sonrasında ilk 72 saat rahimde küçük çaplı kasılmalar olabilir. Özellikle bu dönemde cinsel ilişkiye girmek bu kasılmaların artmasına ve sonucu olumsuz etkileyebileceği ile ilgili çalışmalar olsa da yeteri kadar net kanıt bulunmamaktadır. Bu nedenle embriyo transfer sonrasında genel olarak ilk 3 gün cinsel ilişki önerilmemektedir.
Tüp bebek tedavisi embriyo transferi sonrasında yolculuk yapılabilir özellikle ilk 24 saat istirahat sonrasında yolculuk yapmak embriyo transfer başarısını olumsuz yönde etkilememektedir.
Embriyo transfer sonrasında veya gebelik sürecinde organik olarak adlandırılan içerisinde kimyasal madde barındırmayan saç boyaları kullanılabilmektedir.
Dünyada dondurma ve saklama teknolojilerinde ciddi gelişmeler sayesinde dondurulmuş embriyoların taşınması artık güvenle hiçbir risk olmadan yapılabilmektedir.
Dondurulmuş embriyolar sıvı nitrojen içeren tanklar içerisinde yıllarca saklanabilmektedir. Dondurulmuş embriyo taşınması yine bu sıvı nitrojen içeren bir tankla gerçekleştirilir. Bu nedenle dondurulmuş embriyo taşınmak güvenle yapılabilmektedir.
Dondurulmuş embriyo taşıma için;
Dondurulmuş embriyo taşıma üreme tıbbında çok sıklıkla ve rutin olarak uygulanmaktadır. Bu sayede çiftler dondurulmuş embriyoları ülke içerisinde farklı merkezlere güvenle taşıyabilmektedir. Herhangi bir risk taşımamaktadır.
Çiftler özellikle embriyo taşıma sırasında embriyoların zarar göreceğinden endişe etmektedirler. Embriyolar azot gazı ile dolu olan tanklarda muhafaza edilmektedir. Taşıma işlemi yine sıvı azot içeren başka bir tanka konulmakta ve embryolarda bunun içine yerleştirilmektedir. Bu tanklar sıcaklığı sürekli olarak düşük tutmak için tasarlanmıştır. Bu nedenle zarar görmezler. Uygun talimatlar eşliğinde buna izin veren ülkeler arasında bile embriyo güvenle taşınabilmektedir.
Sevgili çiftlerimiz ve okurlarımız, tüp bebek tedavisi ve kısırlık ile ilgili tüm merak ettikleriniz ve aklınıza gelebilecek her türlü sorunun cevabı için aşağıdaki konularımızı inceleyebilirsiniz. Tüp bebek, kısırlık ve kadın hastalıkları hakkında tüm merak ettikleriniz...

Tüp bebek olarak adlandırılan "in vitro fertilizasyon" laboratuvar ortamında yumurta ve sperm birleştirilerek döllenme sonucu oluşan embriyonun anne rahmine transfer edilmesidir.

Başarı gebelik oranı olarak ifade edildiğinde genellikle artan yaş ile ters orantılı olduğu bilinir. Kadın yaşı arttıkça tüp bebek tedavisi başarısı azalmaktadır.

Yumurta rezervi düşüklüğünü gösteren AMH hormonu kadınların yumurtalık dokusunda öncü yumurta hücresi denilen preantral yumurta hücrelerinden salgılanmaktadır.

Kişiye özel tüp bebek tedavisi çiftlerin tedavi geçmişleri, genetik ve yaşam şekillerini dikkate alıp planlama yapılması esasına dayanır. Bireyselleştirilmiş tüp bebek tedavisi başarı şansını artırabilir.